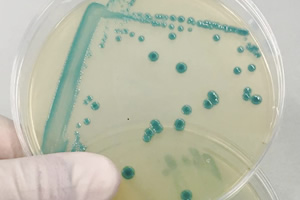
listeria

Una vez que la Listeria se introduce en una planta de procesado de alimentos, ¿sabrías dónde encontrarla?. Esta bacteria es capaz de "instalarse" en superficies y equipos, y permanecer allí durante largos períodos de tiempo, provocando contaminaciones cruzadas recurrentes. Algunas de las claves para su persistencia son su capacidad de crear resistentes biofilms y de adaptarse para sobrevivir a los protocolos de higiene.
Listeria monocytogenes: maestra en persistencia y contaminación cruzada
 Afortunadamente, el número de personas que contraen una infección por consumir alimentos contaminados con Listeria Monocytogenes es relativamente bajo. Sin embargo, este patógeno es una de las principales causas de mortalidad debida a toxiinfecciones alimentarias.
Afortunadamente, el número de personas que contraen una infección por consumir alimentos contaminados con Listeria Monocytogenes es relativamente bajo. Sin embargo, este patógeno es una de las principales causas de mortalidad debida a toxiinfecciones alimentarias.
Está claro que sin una higiene alimentaria adecuada en la cadena de producción de alimentos, la Listeria representa un riesgo para la salud. Pero, incluso con estandares de higiene altos, la Listeria es conocida por su capacidad de sobrevivir en nichos ambientales en los que otros microorganismos no podrían hacerlo.
En este artículo vamos a ver qué es lo que la hace tan especialmente dificil de erradicar, dónde suele ubicarse dentro de las plantas de procesado de alimentos y qué podemos hacer para reducir el riesgo de su proliferación.
Resistencia al estrés ambiental
Una vez que la Listeria monocytogenes accede a una planta de procesado de alimentos, deshacerse de ella es muy difícil. Tolera ambientes salinos, crece en un amplio rango de pH y aguanta temperaturas frías, de hecho puede continuar creciendo a temperaturas tan bajas como -5ºC e incluso puede sobrevivir a los -25 ° C. De modo que la práctica de mantener el producto congelado a temperaturas muy bajas durante un tiempo, como medida para matar a los microorganismos patógenos, no necesariamente funciona con Listeria Monocytogenes.
Además de resistir el embate de factores físicos, la Listeria es también maestra en la defensa frente a los productos químicos utilizados en los protocolos de limpieza e higienización en la industria alimentaria. Un estudio publicado recientemente en la revista Applied and Environmental Microbiology muestra que en determinadas cepas de Listeria, esta capacidad se localiza en dos genes determinados, que actúan como una unidad funcional y aumentan la supervivencia de la bacteria bajo condiciones de estrés alcalino y oxidativo. Asi, ciertos mecanismos genéticos le permiten reaccionar y bloquear los efectos de soluciones limpiadoras y desinfectantes.
Regiones hipervariables del genoma ayudan a la Listeria a sobrevivir
Ciertas regiones fácilmente cambiables del genoma de la Listeria contienen insertos genéticos que le ayudan a sobrevivir. Dependiendo de la cepa bacteriana específica, estas regiones acomodan secuencias de genes diferentes, cuya función es la protección frente a diversos factores de estrés.
Ciertas regiones fácilmente cambiables del genoma de la Listeria contienen insertos genéticos que le ayudan a sobrevivir. Dependiendo de la cepa bacteriana específica, estas regiones acomodan secuencias de genes diferentes, cuya función es la protección frente a diversos factores de estrés.
Los genes de supervivencia al estrés (SSI-1), caracterizados hace ya unos años, le confieren una gran tolerancia frente al estrés ácido, biliar, salino y gástrico. Sin embargo, no explican la capacidad de la bacteria para sobrevivir a las situaciones de estrés provocadas por las acciones de limpieza y desinfección, que principalmente son alcalinas y oxidativas. En estas situaciones se ha hallado recientemente que son dos secuencias genéticas vecinas (SSI-2), dentro de la misma región hipervariable del genoma de la Listeria, las que actúan para protegerla en situaciones alcalinas y oxidativas.
Lo curioso del caso es que esta segunda secuencia genética SSI-2 se encuentra predominantemente en cepas de Listeria Monocytogenes que se especializan en alimentos y en los entornos de procesado de alimentos. La mayoría de las cepas de Listeria encontradas en aislados clínicos no tienen la secuencia SSI-2, por lo que parece propia de cepas que tienen un nicho específico en la industria alimentaria.
Listeria y los biofilms en la industria alimentaria
Por si fueran poco sus habilidades defensivas individuales, la Listeria es también conocida por su capacidad de formar biofilms, y de poder hacerlo además en una gran variedad de superficies utilizadas en la industria alimentaria, representando un serio problema para la seguridad alimentaria.
Las células microbianas dentro del biofilm están organizadas en estructuras complejas, incrustadas en una matriz autoproducida de sustancias poliméricas extracelulares, que pueden adoptar distintas estructuras y que son responsables de la adhesión a las superficies y de la cohesión del propio biofilm. Dentro del biofilm, las células presentan una mayor resistencia a la eliminación y a la destrucción, incluidas las acciones de limpieza, desinfección e higienización.
El biofilm formado por L. monocytogenes es capaz de pegarse a múltiples superficies de contacto con los alimentos, como el acero inoxidable, poliestireno y vidrio, donde se ha visto que puede persistir incluso durante años y causar contaminaciones cruzadas recurrentes de los productos alimentarios.
Aunque la producción de biofilm es significativamente más alta a temperaturas alrededor de los 37 ° C, estudios han comprobado que la Listeria es capaz de formar biofilms incluso a temperaturas tan bajas como 4ºC.
Esta capacidad de L. monocytogenes para producir biofilms a bajas temperaturas, como las utilizadas durante el procesamiento y almacenamiento de alimentos, aumenta significativamente la probabilidad de contaminación cruzada.

La formación del biofilm sigue ciertas etapas: (a) el primer paso se caracteriza por la fijación reversible de células planctónicas en las superficies; (b) las células adheridas comienzan a formar una monocapa y a producir la matriz extracelular; (c) las células dentro de la matriz autoproducida continúan creciendo y formando microcolonias de múltiples capas; (d) las células se fijan irreversiblemente a la superficie y se incrustan en la matriz: en este punto el biofilm ya está maduro; (e) en la última etapa de la formación del biofilm, las células pueden desprenderse de la biopelícula y regresar a la forma planctónica, listas para colonizar nuevas superficies.
¿Dónde buscarla y cómo evitarla?
Visto lo dificil que puede ser erradicar a la Listeria una vez que se instala, ya sea en plantas de procesado, almacenes frigoríficos, centros de distribución, supermercados o restaurantes, lo mejor será poner la máxima atención en prevenirla.
Las cinco áreas más comunes donde podremos encontrarla, si existe contaminación, y dónde debemos aplicar medidas de prevención son: el suelo, los desagües, los equipos de procesado de alimentos, el congelador / sistema de enfriamiento y el sistema de aire acondicionado.
El suelo
Listeria monocytogenes está presente a nuestro alrededor, principalmente en el suelo. Esto hace que su proliferación en la planta de procesado se realice la mayor parte del tiempo a través del calzado. Un requisito importante para evitarla es asegurarse de que el calzado esté limpio en aquellas áreas de la planta que sean susceptibles, como los lugares donde se manipulan alimentos no envasados. Esto puede conseguirse cambiandose el calzado en una compuerta de higiene o sala de cambio. El uso de fundas de plástico para el calzado es menos aconsejable, ya que pueden acumular suciedad o incluso romperse.
Igual de importante que la higiene del calzado, es mantener el suelo seco siempre. La Listeria, igual que la mayoría de bacterias, necesita agua para crecer y persistir, por lo que es importante tener en cuenta los siguientes factores:
- Es importante guiar toda el agua de las líneas de producción en tuberías cerradas e higienizadas de forma regular, hacia el desagüe. Pero, atención, no insertar las tuberías directamente en el desagüe, ya que esto podría generar el crecimiento de bacterias desde el desagüe hacia las tuberías.
- El suelo debe ser inclinado con pendiente hacia el sumidero, colocando el drenaje en el punto más bajo. Esta es la única forma de evitar charcos de agua estancada, que son un riesgo para Listeria Monocytogenes y origen de muchos otros problemas (por ejemplo, moscas).
- En el caso de que se produzca un derrame de producto en el suelo, no use cantidades excesivas de agua para enjuagarlo. Es mucho mejor limpiar el derrame con un cepillo y una bandeja de plástico y solo usar agua (y si es necesario, agentes de limpieza y desinfección) para eliminar los últimos restos de producto del suelo.
Los desagües
 Uno de los lugares donde con más seguridad podremos encontrar a la Listeria, si está presente en las instalaciones, es en los desagües. En ellos se dan las condiciones perfectas para que las bacterias entren y crezcan, ya que a través de los desagües pasa toda el agua sucia, incluida el agua de los procesos de limpieza. A esto hay que añadir que son muchas las instalaciones cuyos desagües no tienen un diseño higiénico adecuado y además no están correctamente ubicados, en el punto más bajo y con todas las superficies del suelo circundantes inclinadas hacia el desagüe.
Uno de los lugares donde con más seguridad podremos encontrar a la Listeria, si está presente en las instalaciones, es en los desagües. En ellos se dan las condiciones perfectas para que las bacterias entren y crezcan, ya que a través de los desagües pasa toda el agua sucia, incluida el agua de los procesos de limpieza. A esto hay que añadir que son muchas las instalaciones cuyos desagües no tienen un diseño higiénico adecuado y además no están correctamente ubicados, en el punto más bajo y con todas las superficies del suelo circundantes inclinadas hacia el desagüe.
Además de utilizar un drenaje de diseño higiénico, también es importante mantenerlo limpio y desinfectado en todo momento. De lo contrario, acaba siendo un lugar elegante y caro para que las bacterias se multipliquen. Por esto es importante poner un desinfectante en el drenaje después de cada ciclo de limpieza. De esta forma, el agua estancada en el desagüe se mantendrá limpia y desinfectada. k if the chlorine tablet is still present.
Los equipos
 Además de suelos y desagües, es importante asegurarse de que Listeria Monocytogenes no encuentre lugares donde instalarse y crecer en los equipos de procesado de alimentos. Aqui entra de nuevo en juego el diseño higiénico de dichos equipos: con superficies son lisas y diseñadas para una fácil limpieza (sin grietas, ni ángulos agudos).
Además de suelos y desagües, es importante asegurarse de que Listeria Monocytogenes no encuentre lugares donde instalarse y crecer en los equipos de procesado de alimentos. Aqui entra de nuevo en juego el diseño higiénico de dichos equipos: con superficies son lisas y diseñadas para una fácil limpieza (sin grietas, ni ángulos agudos).
Los lugares donde más probablemente existirá riesgo de contaminación con la bacteria sin que sea percibida son aquellos que necesitan una limpieza manual, los que tienen grietas y, a menudo, los que tienen agua estancada.
Cuanto más cerca esté el producto no envasado de aquellos puntos con agua estancada frecuente, mayor es el riesgo potencial de introducir Listeria Monocytogenes en el flujo de producción. Es necesario mantener el agua estancada lejos del producto abierto siempre, como mínimo a dos metros. Si no es posible mantener esta regla, hay que considera rediseñar el equipo o reubicar la fuente de agua.
Aparte del diseño de los equipos, hay que ser siempre prudente con el uso del agua, y especialmente NO utilizar nunca agua a altas presiones en los sistemas manuales de irrigación. El agua a alta presión forma aerosoles, que son el mecanismo de transporte perfecto para las bacterias y podrian ser una forma perfecta para la proliferación de Listeria en las instalaciones.
El congelador / sistema de enfriamiento
 Otra área donde la Listeria puede esconderse es en el congelador o en los sistemas de enfriamiento. Estos equipos tienen placas de evaporación internas, que se descongelan automáticamente de forma regular para evitar la acumulación excesiva de hielo en las placas. Junto a estas placas, se encuentra un ventilador, que fuerza el desplazamiento del aire para enfriar el área circundante.
Otra área donde la Listeria puede esconderse es en el congelador o en los sistemas de enfriamiento. Estos equipos tienen placas de evaporación internas, que se descongelan automáticamente de forma regular para evitar la acumulación excesiva de hielo en las placas. Junto a estas placas, se encuentra un ventilador, que fuerza el desplazamiento del aire para enfriar el área circundante.
En la prevención de Listeria Monocytogenes es primordial mantener las placas de evaporación limpias y desinfectadas en todo momento. Como ya hemos visto, Listeria Monocytogenes puede sobrevivir a temperaturas muy bajas e incluso crecer a temperaturas tan bajas como -5˚C. Por esta razón, es necesario asegurarse de limpiar y desinfectar regularmente las placas de evaporación y los ventiladores de todos los sistemas de refrigeración y congelación.
El sistema de aire acondicionado
Igual que el congelador y los sistemas de enfriamiento, el sistema de aire acondicionado en planta de producción puede usar placas de evaporación para ajustar la temperatura del aire. Todas las medidas de higiene adoptadas para el congelador y los sistemas de enfriamiento también son aplicables al sistema de aire acondicionado.
Pero, además, para estos últimos hay otro aspecto que también se debe tener en cuenta: la probabilidad de acumulación de agua (a través de la condensación) dentro de los conductos de transporte de aire y de las rejillas de ventilación que van a dar a la fábrica.
Es aconsejable realizar una inspección con un boroscopio (sonda con cámara) después de una limpieza manual en las instalaciones (cuando hay mucho excedente de agua en el aire) para ver si hay acumulación de agua en el sistema de aire acondicionado.
Fuentes:
- https://www.foodsafety-experts.com/
- Listeria monocytogenes Biofilms in the Wonderland of Food Industry, Pathogens 2017
-
Stress Survival Islet 2, Predominantly Present in Listeria monocytogenes Strains of Sequence Type 121, Is Involved in the Alkaline and Oxidative Stress Responses, Applied and Environmental Microbiology 2017

Higiene Ambiental Consulting, junto con Ambientalys, hemos desarrollado una formación técnica especializada, con el objetivo de formar acerca de cómo se desarrolla esta bacteria dentro de la industria alimentaria, dar a conocer las estrategias, técnicas y productos para controlarla y aprender a identificar los sistemas de detección y prevención más adecuados.
Esta formación se imparte en modalidad on-line y tiene una duración de 25 horas.
Más información sobre el Curso on-line: Listeria: prevención y control en la industria alimentaria

